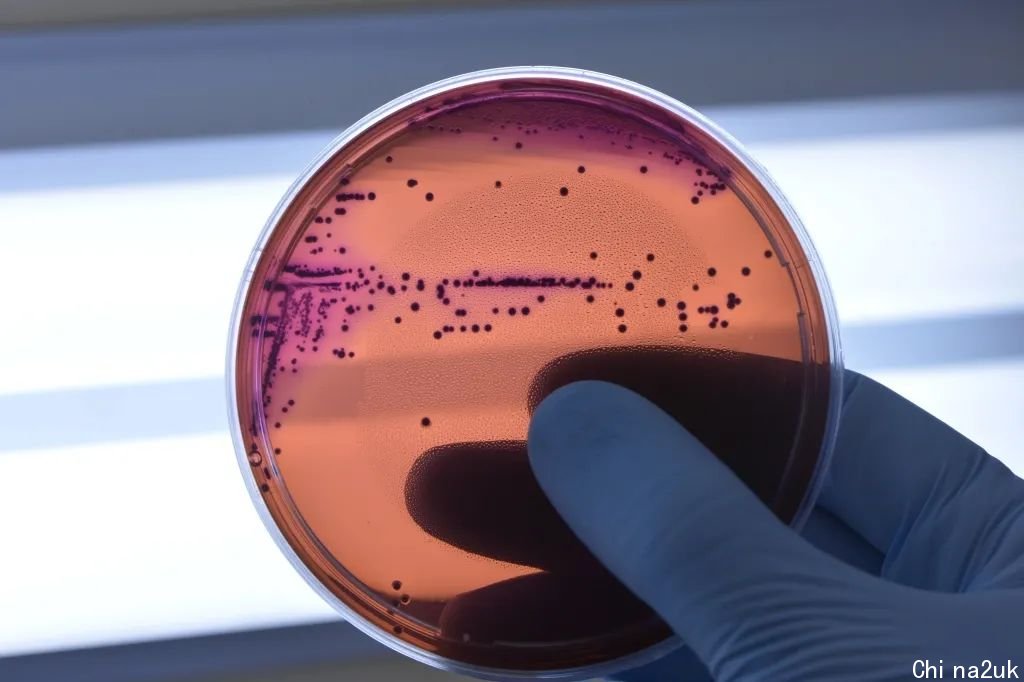

英国论坛
英格兰R值降至0.7-0.9
据国度统计局(ONS)4月29日公布的最新数据,估量英格兰感染率R值在0.7-0.9之间。这一数字象征着,每10个感染者会感染7-9个其余人。
最新增长率在-6%和-3%之间,象征着新感染者的数量以天天6%和3%的速度缩减。

图片来源GOV.UK
丹麦暂停新冠疫苗接种
丹麦政府4月28日(周四)表现,该国在5月15日之后将再也不发送新冠疫苗接种预定约请。成为世界首个暂停新冠疫苗接种的国度。
始终以来,丹麦在放宽限度和社会凋谢方面都当先于欧洲其余国度。往年2月,该国就宣告“与新冠共存”,并勾销了一切新冠限度。

图片来源NewScientist
丹麦沾染病主任Bolette Søborg告知法新社,斟酌到丹麦目前免疫程度高,病例增加,住院率趋于不乱,抉择逐渐完结大范围新冠疫苗接种方案。
她也表现,被迫持续实现疫苗接种的特殊高危群体,以及无意向接种疫苗的人仍能够获取疫苗接种。

丹麦疫苗接种比率 | 图片来源OurWorldInData

丹麦单日新增确诊变动 | 图片来源Reuters Data

丹麦住院数据变动 | 图片来源OurWorldInData
在丹麦580万人口中,超过五分之四(82%)彻底接种了新冠疫苗(两针剂);61.6%的人接种了增强剂疫苗。按照4月26日的数据,该国过来七天单日新增1,549例确诊病例。自4月初以来,因新冠住院的人数在1,000人下列。
但是,丹麦当局也表现,预计跟着冬天到来,感染会减少,并且新冠病毒会跟着时间推移产生变异,所以不排除在秋天从新启动接种方案的可能。

图片来源RitzauScanpix/AFP via GettyImages
上周,因为耽心少部份接种者会泛起极其稀有但重大的血栓反作用,丹麦宣告片面住手接种阿斯利康疫苗(AstraZeneca),并敦促其余国度也应暂停接种该公司疫苗,这惹起了争议。在暂停接种时,已有超过15万名丹麦人接种该疫苗。
早前,瑞典和荷兰宣告住手接种阿斯利康疫苗。但欧盟卫生官员民间公布支持意见,并表现应由各成员国做出本人的抉择。

图片来源CNN
健达牌巧克力或与
沙门氏菌中毒事情无关
世界卫生组织(WHO)于4月27日(周三)表现,在英国监管机构一个月前发现一组沙门氏菌(S. Typhimurium)病例后,在寰球包罗比利时、法国、德国、爱尔兰、卢森堡、荷兰、挪威、西班牙、瑞典、英国和美国,十一个国度中讲演了151例可能与健达巧克力相干的沙门氏菌病疑似病例。
这些巧克力曾经销往最少十一3个国度和地域,其中包罗中国。

图片来源UNNews
钻研讲演显示,目前确实诊病例中,10岁下列的儿童约占病例的89%,有9名患者住院医治,目前尚无死亡病例。这些病例均在食用了巧克力制作商费列罗Ferrero旗下健达“奇趣蛋”(Surprise)后泛起了腹泻和呕吐的景象。
随后,在该品牌在比利时Arlon运营的一家工厂中发现了与目前人类感染病例相婚配的沙门氏菌。据媒体报导,该工厂在本月初被勒令临时封闭。

图片来源Shutterstock/Pixabay
国内食物平安当局网络(INFOSAN)于4月10日公布了寰球警报,启动寰球产品召回。
联结国机构在一份声明中说,“在获取对于片面召回产品的信息以前,世卫组织对该病例在欧洲地域和寰球的传布危险被评价为中等”。

图片来源GettyImages
沙门氏菌病特征是泛起急性发热、腹痛、恶心、呕吐和腹泻,在大少数状况下,患者不需求特殊医治就会痊愈。症状通常在摄取被沙门氏菌净化的食品或水后6至72小时开始,病症可继续2至7天。
据统计,在世界各国的品种细菌性食品中毒中,沙门氏菌惹起的食品中毒常列榜首。但尚无人由于食用巧克力感染沙门氏菌死亡的例子。
图片来源WorldStockMarket
女王白金禧年庆典
1,500万英镑压轴节目地下
据天空旧事(SkyNews)报导,女王白金禧年庆典1,500万英镑压轴节目已地下!组织者说,这场耗资千万英镑的庆典将是“终身只要一次”的阅历。
据理解,这笔钱由企业资助商和集体筹集。

图片来源HeartRadio
黄老板Ed Sheeran领衔音乐家现场live show、柯基犬木偶和女王巨型3D半身像将节压轴表态狂欢节庆典。


图片来源TheTimes/SkyNews
女王白金禧年庆典将于6月5日(周日)下昼在白金汉宫及其四周长达3千米的街道进行,以记念女王在位70周年银行假期的最初一天。
庆典亮点还包罗空中艺术家、微小橡树安装艺术、蒲月花柱舞者(maypole dancer)、挪动婚礼蛋糕等其余花车游行队伍。





图片来源SkyNews
庆典导演David Zolkwer表现,该流动将分为四个部份。第一部份将有1,750人和200匹马加入阅兵,作为古代历史上最大的军事扮演之一。
但他没有透露无关王室“阳台表态”的任何进一步细节,但愿“为当天保存一些惊喜”。


图片来源SkyNews
David Zolkwer表现,“这是一场对于分享回想、故事和阅历的庆典,能够看到咱们是如何经过时间、彼此和女王分割在一同的”。
预计届时超过10,000人将参预现场,包罗戎行、6,000多名意愿者、扮演者和次要任务人员以及2,500名大众。寰球将有多达10亿人在线观看。

图片来源SkyNews
蒲月银行假期周末
数百万人堕入出行凌乱
复活节假期的旅行凌乱曾经继续至5月的第一个银行假日周末!旅客纷纭表现英国各地机场排队时间超过2小时。
航空公司已向乘客发送通知,倡议其提前最少3-4个小时抵达机场,以避免以及错过航班。


图片来源Twitter@DailyMailUK/TheDailyExpress
希思罗机场的一位乘客在社交媒体上写道,“有太多的人。队伍始终排到航站楼的止境”。
希思罗机场发言人表现,“这是一个十分忙碌的周末,使人遗憾的是,在离境大厅泛起了延误。咱们曾经部署了额定的任务人员,与疆域部队协作,以尽快解决这类状况”。





图片来源Reuters/Twitter@statsjamie/TheMirror/iNews
银行假期面临出行凌乱的不单单是飞机乘客。因为歇工行为和工程名目的继续,铁路办事也面临间断。

图片来源DailyMail
因为铁路、海运和运输(RMT)工会成员正在进行对于工资和轮值表纷争的歇工流动,横跨英格兰北部和苏格兰的TransPennine Express(TPE)呐喊乘客尽可能不要在4月30日-5月1日(周六/日)出行。
该公司在此期间仅运转“极多数线路“。

在银行假日期间,铁路网将持续推动550个降级名目,几条铁线路受影响封闭:
次要受影响路线

图片来源DailyMail
其余受影响路线

图片来源DailyMail
只管英国皇家汽车俱乐部(RAC)预估,5月2日(周一)银行假期期间约有330万辆私家车出行。但因为两礼拜前才是复活节,加之行将到来的半学期假期、高油价和温和的天气,英国的路途预计将比正常的银行假日周末更平静。


图片来源Petermacdiarmid/LNP/Twitter@DirectTrip
热战以来最大军事部署!
数千名英国戎行将被派往欧洲
约8,000名英国士兵将被派往东欧,加入自热战以来范围最大的一次,由芬兰到北马其顿的国度级军事部署。
据悉,几十辆坦克和100多辆装甲战车也将在往年夏天被部署到位,加入军事演习。

图片来源SkyNews
据报导,来自北约(NATO)和远征军联结部队(Joint Expeditionary Force)的数万名士兵将参加武装部队,其中包罗丹麦、冰岛和挪威等国。
英国预计将在4月至6月期间部署共计约8,000名人员。一些演习将波及下降伞投放、直升机空中突击、Challenger 2型坦克。
本周将在北马其顿开始一项由16空中突击旅战役队(16 Air Assault Brigade Combat Team)和1航空旅战役队(1 Aviation Brigade Combat Team )参预的人员演习。


图片来源ina.iq/Janek Skarzynski/AFP via Getty Images
英国国防部表现,方案演习将进步英国和芬兰部队的并肩作战才能,“以在斯堪的纳维亚半岛和波罗的海国度增强对俄罗斯的进攻”。
英国国防部长Ben Wallace说:“欧洲的平安从未像当初这样首要。此次军事演习将看到英国部队与北约和远征军联结部队盟友联手,在热战以来最大的一次独特部署中展现团结和气力“。
此外,与美国戎行一同进行的演习也将在波兰进行。

图片来源AP
俄乌危机最新停顿更新
乌克兰抵赖在俄罗斯对东部的攻打中“损失惨痛”。随后,美国总统拜登呐喊国会向乌克兰领取多达330亿美元的资金帮忙抵挡攻打。
马里乌波尔Mariupol市长表现,在俄罗斯的轰炸中,Azovstal钢铁厂内的暂时病院设施受到毁坏,预计伤者超过600人。俄乌仍在就如何撤退钢铁厂内的平民进行探讨,联结国在拜候两国期间,也表现将提供帮忙。

图片来源BBC
英国内政部称,一位英国人在乌克兰确认死亡,另有一位失踪,但尚未发布两人的身份。内政动静人士表现,这两人极可能是在马里乌波尔Mariupol或顿巴斯Donbas其余中央为乌克兰武装部队办事的本国意愿军。
来自乌克兰的动静人士称,死者名为Scott Sibley,是一位前英国武装部队成员。也是第一个被证明在俄乌冲突中死亡的英国人。对于他死亡的细节以及另外一人失踪的形式和时间都没有发布。

Scott Sibley | 图片来源BBC
印度尼西亚总统Joko Widodo在4月29日(周五)的一份声明中说,俄罗斯总统普京已承受约请,列席将于十一月在巴厘岛举办的G20峰会。同时,在早些时分也向乌克兰总统泽连斯基收回了约请,但仍未失掉列席回复。
印度尼西亚内阁在声明中说,“印度尼西亚但愿将20国团体团结起来。不要泛起分裂。战争与不乱是世界经济复苏和开展的症结“。
印度尼西亚早前表现,筹备向乌克兰提供人道主义支援,但不提供军事支援,由于该国的宪法和内政政策准则阻止这一做法。

图片来源TheDiplomat

















